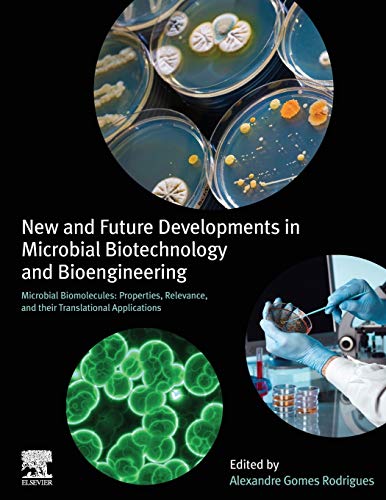

New and Future Developments in Microbial Biotechnology and Bioengineering: Microbial Biomolecules: Properties, Relevance, and Their Translational Applications (PDF Book)
New and Future Developments in Microbial Biotechnology and Bioengineering: Microbial Biomolecules: Properties, Relevance and Their Translational Applications presents a concise review on microbial biotechnology, along with impacts and recent results from research centers, small companies and large enterprises. The book brings the most relevant information on how we can use resources―in this case from microorganisms―and technology to develop solutions in fields like biofuels, food, cosmetics and medicine. It covers case studies of start-ups in the field and explains how scientists have moved their ideas into profitable bio-based products that are necessary for our current living standards.
In addition, the book describes strategic governmental programs designed to exploit biomass in a sustainable way, along with detailed information on research in several high-impact, worldwide laboratories. It gives concrete examples of ongoing research from molecules to methods, such as L-asparaginase, extremophiles, new diagnostics tools and the analytical methods that have raised the quality of the data obtained, thereby boosting the so-called bioeconomy.
Product Details
- Item Weight:2.29 pounds
- Digital eBook:374 pages
- ISBN-10:044464301X
- ISBN-13:978-0444643018
- Product Dimensions:8.5 x 0.78 x 11 inches
- Publisher:Elsevier; 1st Edition (June 22, 2020)
- Language::English